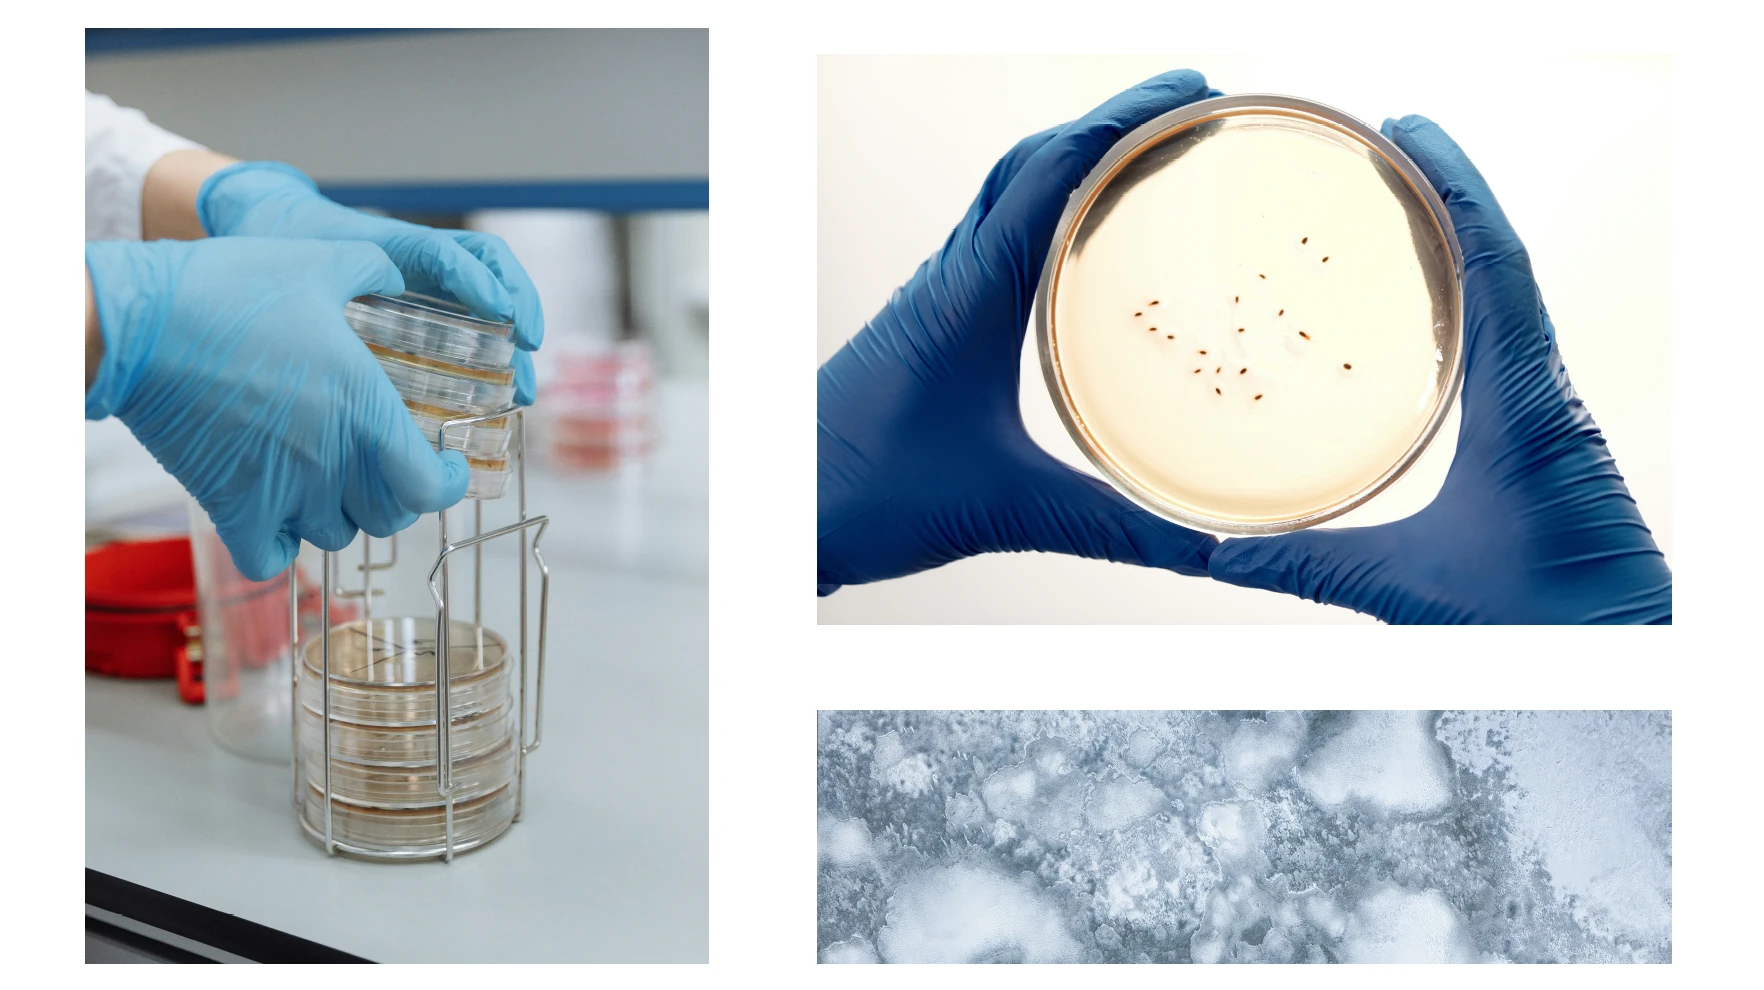

Brand ID & Web Design for an Innovative Concrete Manufacturer

Overview
A brand and visual design system developed for a Portland-based concrete manufacturer, focused on advancing innovation in construction materials. Among its research initiatives is self-healing concrete, a material that repairs its own cracks through embedded biological processes.
Naming
The name ASP is derived from Joseph Aspdin, the English bricklayer who invented Portland cement in 1824. His discovery transformed construction by enabling the development of modern concrete — the structural foundation of contemporary cities.
Referencing his name anchors the brand in the origin of modern concrete, while positioning the company as a continuation of that spirit of experimentation.

Main Visual Illustration
The Challenge
Concrete is one of the most widely used materials in the world, yet the industry often communicates through highly technical or purely industrial language.
The challenge was to develop a design system that could:
• Communicate innovation in material research
• Translate complex processes such as self-healing concrete into visual form
• Expand beyond industrial communication into cultural and editorial contexts
The goal was to reposition the company as a material innovator rather than simply a manufacturer.

Packaging


Strategic Approach
The concept centers on concrete as a living material.
Self-healing concrete introduces biological processes into a traditionally inert substance, allowing the material to repair itself when cracks appear. This transformation reframes concrete as responsive, adaptive, and regenerative.
Homepage Design

Typography

Editorial Design
Editorial Platform
Beyond engineering and construction, the project explores concrete as a cultural material.
An editorial component highlights artists and designers who use concrete as a medium for experimentation and expression. Through interviews, publications, and visual documentation, the platform reveals a different dimension of the material — one that exists between architecture, sculpture, and design.
An editorial component highlights artists and designers who use concrete as a medium for experimentation and expression. Through interviews, publications, and visual documentation, the platform reveals a different dimension of the material — one that exists between architecture, sculpture, and design.
By juxtaposing material science with artistic exploration, the brand expands the perception of concrete from infrastructure to cultural artifact.

Impact
ASP positions the company within a broader narrative that spans historical invention, contemporary research, and cultural experimentation.
The design system creates a coherent framework through which technological innovation, material heritage, and artistic practice can coexist.
Rather than presenting concrete purely as an industrial product, the brand reframes it as a material with both structural and cultural significance.
Like this project
Posted Mar 8, 2026
A brand identity system for a concrete manufacturer pushing the material into a new visual territory.
